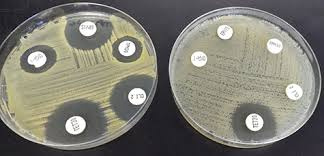

آخرین ویرایش۲۰ آذر ۱۴۰۳
اخبار مرتبط
تعیین خواص ضد میکروبی (باکتری و مخمر) نمونه های گی...
آنالیزهای آنتی باکتریال برای کلیه مواد و پلیمرهای سنتز شده ب...

مجموعه تستهای کنترل میکروبی گلاب و عرقیات
در این آزمون کلیه آنالیزهای مربوط به گلاب و عرقیات طبق استانداردها...

بررسی اثرات ضد میکروبی (آنتی باکتریال) به روش تعیی...
در این آنالیز تعداد میکروارگانیسمهای مورد نظر در زمانهای مشخص پس ا...

آزمایشگاه میکروبیولوژی
آزمایشگاه میکروبیولوژی مجهز به دستگاههای مختلف از جمله هود لامینار، ات...



نظر شما :